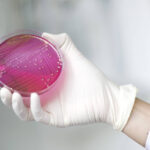

Ликбез от врача по пластике груди: вызовет ли рак, нужно ли менять импланты

Есть ли у грудных имплантов срок годности, осложнят ли они диагностику рака молочных желез, и могут ли они понадобиться мужчинам? На эти и другие вопросы в интервью NEWS.ru ответила пластический хирург Софья Абдулаева.
Есть ли у грудных имплантов срок годности
Установка грудных имплантов является безопасной и пожизненной процедурой. Пациенту достаточно проходить ежегодное ультразвуковое исследование для исключения риска разрыва. Любой имплант, который устанавливается под молочную железу, — бессрочный. Перед своей установкой он проходит огромное количество проб на безопасность.
К каждому изделию обычно прилагается руководство с серийным номером и наименованием производителя. В случае повреждения импланта компания обязана бесплатно заменить его по результатам экспертизы, если будет доказано, что порча произошла без участия хирурга или пациента.
Существуют теории о повторной переустановке после 5–10 лет службы, однако пациенту достаточно проходить ежегодное УЗИ. При замене импланта нужно учитывать срок его ношения и особенности установки.
В каких случаях грудной имплант нужно менять
Прорыв жидкой части импланта является веским поводом для его замены. Врачи дают пожизненную гарантию на свою работу, однако неправильно подобранный размер изделия может спровоцировать повторное вмешательство. Все изделия ударопрочные, высокое качество силикона гарантирует их целостность.
При этом пациентам нужно быть готовыми к повторному вмешательству. Установка большого импланта в маленький карман приводит к трению, что может вызвать разрыв оболочки изделия.
Если нерожавшая женщина с маленьким количеством покрывной ткани захочет сразу установить большой имплант, то с первого раза это не получится. Сначала ей нужно поставить имплант соизмеримой ширины. Через пару лет женщине можно смело установить имплант побольше, и тогда речь идет о повторном хирургическом вмешательстве.
Влияют ли грудные импланты на результаты маммографии
Грудные импланты могут затруднить выявление рака груди при маммографии. Их наличие снижает видимость ткани на 10–20%. Изделия влияют на интерпретацию результатов исследования, но не делает его бесполезным или невозможным. В сложных ситуациях применяются особые методы съемки, в том числе техника Эклунда, когда имплант временно сдвигают, а железу слегка подтягивают вперед. Это позволяет получить более четкое изображение ткани.
Что касается ложноотрицательных результатов — в зоне, перекрытой имплантом, можно пропустить микрообызвествления (ранний признак онкологии). С другой стороны, сами импланты не увеличивают риск рака груди, кроме редкой анапластической крупноклеточной лимфомы, связанной с текстурированными имплантами. Пациентам предпочтительнее делать УЗИ и МРТ, нежели маммографию.
Какого специалиста нужно посетить перед пластикой груди
Перед пластикой груди женщина должна исключить дисморфоманию — чрезмерную обеспокоенность незначительным или воображаемым дефектом внешности стоит обсудить с психотерапевтом. Зачастую то, что кажется нам недостатком, на самом деле является индивидуальной особенностью, делающей нас уникальными. Перед операцией нужно также посоветоваться с друзьями и родственниками.
Важно дать себе время подумать, прежде чем принимать окончательное решение. Изменения во внешности — это серьезный шаг, который требует осознанного подхода. Помните, что красота — это не только внешность, но и внутреннее состояние. Любите и принимайте себя такими, какие вы есть.
Может ли искусственная грудь обвиснуть
Женская грудь может обвиснуть из-за слишком больших имплантов. Это явление, называемое птозом молочной железы, обусловлено естественными возрастными изменениями, гравитацией и другими факторами.
Почему так происходит? Во-первых, с возрастом теряется эластичность кожи, а поддерживающие связки ослабевают. Гравитация также оказывает постоянное давление, растягивая ткани. Значительные колебания веса и беременность с последующим кормлением грудью могут дополнительно растянуть кожу, снижая ее упругость. Размер и вес имплантов играют существенную роль в обвисании — более крупные и тяжелые импланты создают дополнительную нагрузку, увеличивая риск птоза.
Еще одним осложнением может стать так называемый синдром водопада, который представляет собой специфическую деформацию груди. Это происходит из-за несоответствия между положением импланта и тканей молочной железы. Качество кожи также имеет значение — у женщин с тонкой кожей птоз может развиться быстрее.
В каких случаях грудные импланты понадобятся мужчинам
Грудные импланты могут быть рекомендованы мужчинам при атрофии мышечной ткани и после травм. Хирургическое вмешательство производится не только для изменения внешнего вида, но и для восстановления после операций.
В редких случаях, при некоторых неврологических заболеваниях или в результате длительной иммобилизации, может наблюдаться атрофия грудных мышц. Имплантация может быть рассмотрена для восстановления формы. В случаях, когда после травм или хирургического вмешательства происходит значительная потеря объема грудных мышц, импланты могут быть использованы для восстановления контуров тела.
Операция также рекомендуется при синдроме Поланда. Данный врожденный дефект проявляется отсутствием или недоразвитием большой грудной мышцы с одной стороны тела. Некоторые деформации, такие как воронкообразная грудь, могут создавать впечатление западения грудной клетки. Хотя импланты не исправляют основную проблему, они могут визуально улучшить внешний вид, сглаживая неровности.
Какова средняя стоимость пластики груди в России
Стоимость маммопластики в России варьируется от 300 тыс. до 2 млн рублей. Окончательный ценник зависит не только от качества самих имплантов, но и сложности операции. Более современные и технологичные импланты, например анатомической формы или с особой поверхностью, обойдутся дороже стандартных круглых.
Сложность операции, выбранный метод доступа (через подмышечную впадину или под грудью), необходимость дополнительных манипуляций, например коррекция асимметрии, — все это влияет на итоговую стоимость. Эндоскопические методики всегда дороже из-за затрат на аренду оборудования. Если требуются дополнительные вмешательства помимо установки импланта, например коррекция птоза (подтяжка груди), стоимость операции увеличится.
:
Хирург развеял главные мифы об опасности грудных имплантов
Пластический хирург раскрыл связь карьеры с внешностью
Названы топ-5 причин сразу сменить пластического хирурга
Названы пластические операции с быстрым визуальным эффектом
Хирург назвал самые популярные пластические операции у мужчин